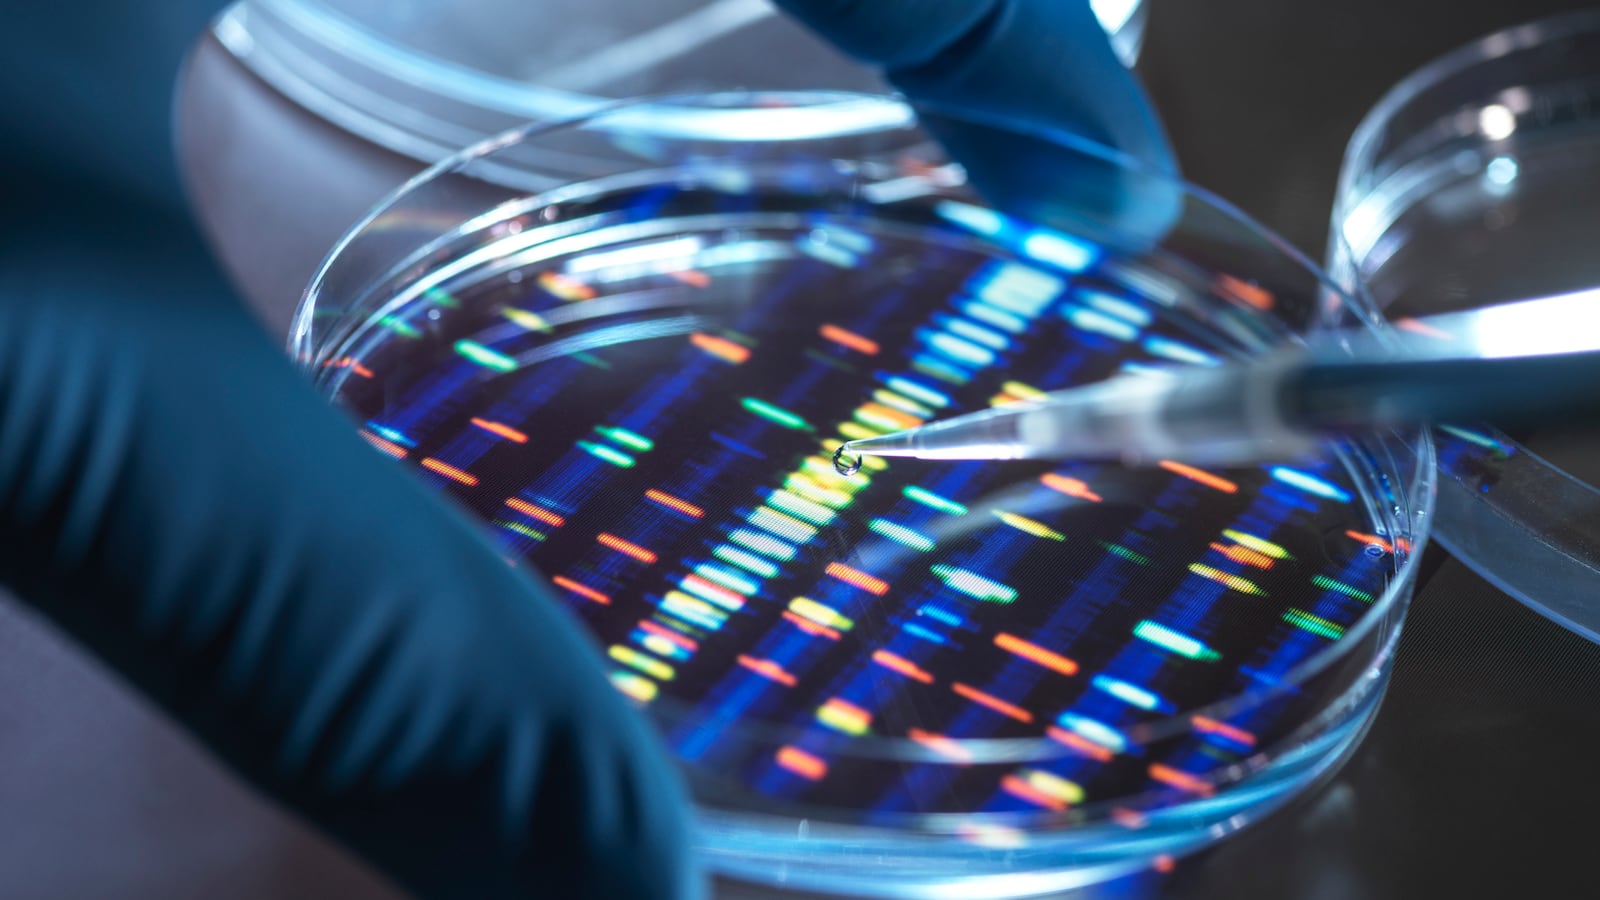
DNA testing

A charred skeleton discovered by a hiker outside San Bernardino, California, in 1970 was a John Doe for half-a century. But with recent advances in DNA analysis, detectives decided to send a bone fragment to a private lab to see if they could put a name to the corpse. KTLA reports that the lab was able to create a genetic profile for the man and use that to find possible relatives and come up with his identity: James Hollowell Harvey, born in 1913. Authorities still don’t know how he died, however.
Read it at KTLA